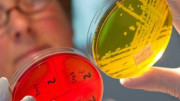

Общество
Лента новостей
28.01, 05:05
Свердловский театр музкомедии покинет Екатеринбург
27.01, 23:02
Свердловские биатлонисты принесли России победу на этапе Кубка Содружества в Белоруссии
27.01, 11:45
В Нижнем Тагиле сменился глава ГАИ
27.01, 10:30
Гендер-пати на главной площади: почему здание мэрии Екатеринбурга внезапно стало голубым
27.01, 09:05
Правда вскрылась только через год: на Урале судят гинеколога за лишение пациентки возможности стать матерью
28.01, 06:34
Сушёная опасность с диоксидом серы и плесенью: 2 способа правильно мыть сухофрукты, чтобы не отравиться

Обращение Госавтоинспекции в связи с неблагоприятными погодными условиями

Взрослую поликлинику в Среднеуральске возглавил врач-нейрохирург

В Верхней Пышме на карантине находятся 11 групп в детских садах и 7 классов в школах

В Среднеуральске обещают отремонтировать больницу и обновить медкабинеты на 6 миллионов
В Среднеуральске зарегистрировано 138 случаев острых кишечных инфекций среди детей. Данные предоставлены Роспотребнадзором за 2018 год

Морозы из Верхней Пышмы и Среднеуральска уйдут, но вернутся. Синоптики рассказали о погоде на неделю

«Мы работаем с существенными перегрузками». В больнице Верхней Пышмы вырос приток пациентов

Областные врачи обследуют всех желающих на базе Верхнепышминской ЦГБ

В Среднеуральске работает «горячая линия» по качеству молочной продукции
Популярное
22.01, 03:05
И все-таки они прилетят: стали известны имена известных фигуристов, которые выступят в Екатеринбурге
28.01, 05:05
Свердловский театр музкомедии покинет Екатеринбург
22.01, 14:12
Ушел на прогулку и погиб: в Ревде простятся с 36-летним мужчиной, пропавшим в новогодние каникулы
25.01, 09:20
В Екатеринбурге облили кислотой многодетную мать
21.01, 17:05
Глава минздрава «разнесла» ремонт в 2-х поликлиниках Каменска-Уральского и извинилась перед горожанами
23.01, 11:10
15 лошадей погибли при пожаре в конюшне в Заречном
24.01, 10:53
Лютые морозы задержатся на Урале
22.01, 16:05
Откуда у людей деньги: в 2026 году екатеринбуржцы намерены в среднем накопить 409 тысяч рублей
25.01, 11:06
В Рефтинском сгорела птицефабрика










